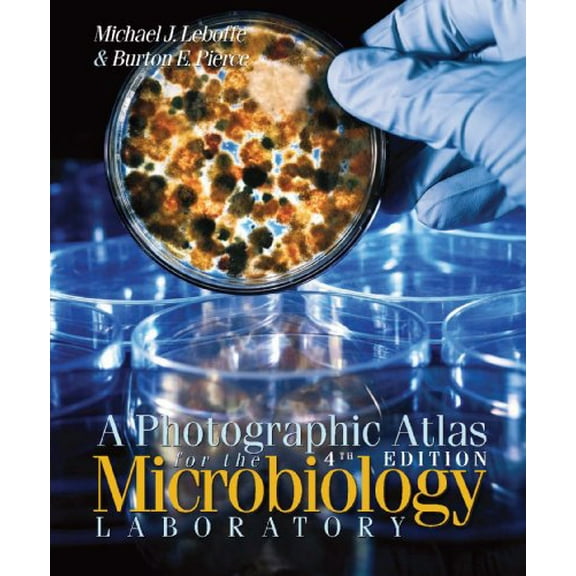
Pre-Owned A Photographic Atlas for the Microbiology Laboratory (Loose Leaf) 0895828723 9780895828729

Hero image 0 of Isolation and Characterization of the Pha Producing Bacteria (Paperback), 0 of 1
Isolation and Characterization of the Pha Producing Bacteria (Paperback)
(No ratings yet)
Current price is USDNow $13.35
You save $16.65
was $30.00
Price when purchased online
Out of stock
How do you want your item?
Out of stock
About this item
Customer ratings & reviews
0 ratings|0 reviews
This item does not have any reviews yet